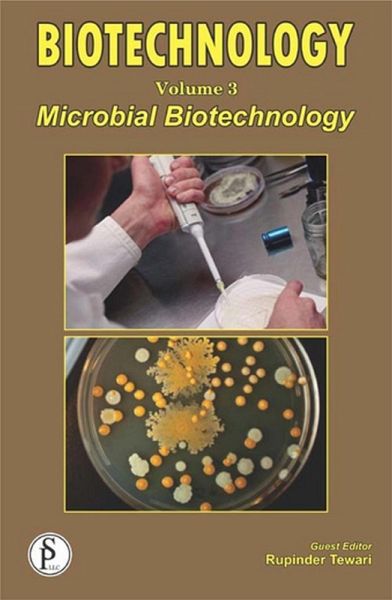

Biotechnology (Microbial Biotechnology) (eBook, ePUB)
PAYBACK Punkte
233 °P sammeln!
The influence of modern techniques on different branches of microbiology such as agriculture, environment, industrial, medical, etc. has been tremendous. The major aspect of modern techniques has been on better understanding of the inherent nature of enzymes, thereby, opening new vistas to alter their native characteristics, like catalytic activity, substrate specificity and heat and pH stability. The plethora of scientific information available has also led to better understanding of folding and denaturation mechanisms of proteins. The present volume covers these and many other developments m...
The influence of modern techniques on different branches of microbiology such as agriculture, environment, industrial, medical, etc. has been tremendous. The major aspect of modern techniques has been on better understanding of the inherent nature of enzymes, thereby, opening new vistas to alter their native characteristics, like catalytic activity, substrate specificity and heat and pH stability. The plethora of scientific information available has also led to better understanding of folding and denaturation mechanisms of proteins. The present volume covers these and many other developments made in the fields of microbiology and biotechnology in recent past for the benefit of under graduates, post graduates and research scholars doing course work in colleges, universities and research centers. Topics being covered in this volume are: oMolecular biology of microbial polygalacturonases oLipase/esterase-catalyzed synthesis of aliphatic polyesters oPhysiological and biotechnological applications of proteolysis enzymes oMolecular engineering for microbial lipases with organic solvents tolerance oImproving microbial xylanases for commercial applications oAdvances in applications and future prospects of microbial exopolysaccharides oPhosphate regulation in the antibiotic-producers streptomycete oBacterial adrenergic receptor kinesis for host-pathogen cross talk oCurrent research and future directions on biofilms in chronic wounds oPeptide antibiotics of haloarchaea as an alternative to clinical antibiotics oMechanisms behind the establishment of coagulate negative Staphylococci as successful nosocomial pathogens oRecent advances and challenges in microbial biotechnology oIndustrial applications of microbial biotechnology oBiotechnological properties of autochthonous yeasts in winemaking oSynthesis and applications of microalgae bibfuls oExploring bacteria as potential bio-fertilizers for agricultural crops oMarine entophytic fungi productivity oSynergistic effects of proboscis and prebiotics on human health oFood grade microbial pigments oBiosurfactant based production of Bacillus and Pseudomonas bio-control agents oBiochemical routes for biogas production and controlling factors This volume contains 21 chapters from 58 researchers and/or academicians representing 6 nations, namely Brazil, China, Egypt, India, Spain and United States of America giving an overview of the various research activities being carried out in different parts of the world on Microbial Biotechnology.
Dieser Download kann aus rechtlichen Gründen nur mit Rechnungsadresse in A, B, BG, CY, CZ, D, DK, EW, E, FIN, F, GR, HR, H, IRL, I, LT, L, LR, M, NL, PL, P, R, S, SLO, SK ausgeliefert werden.